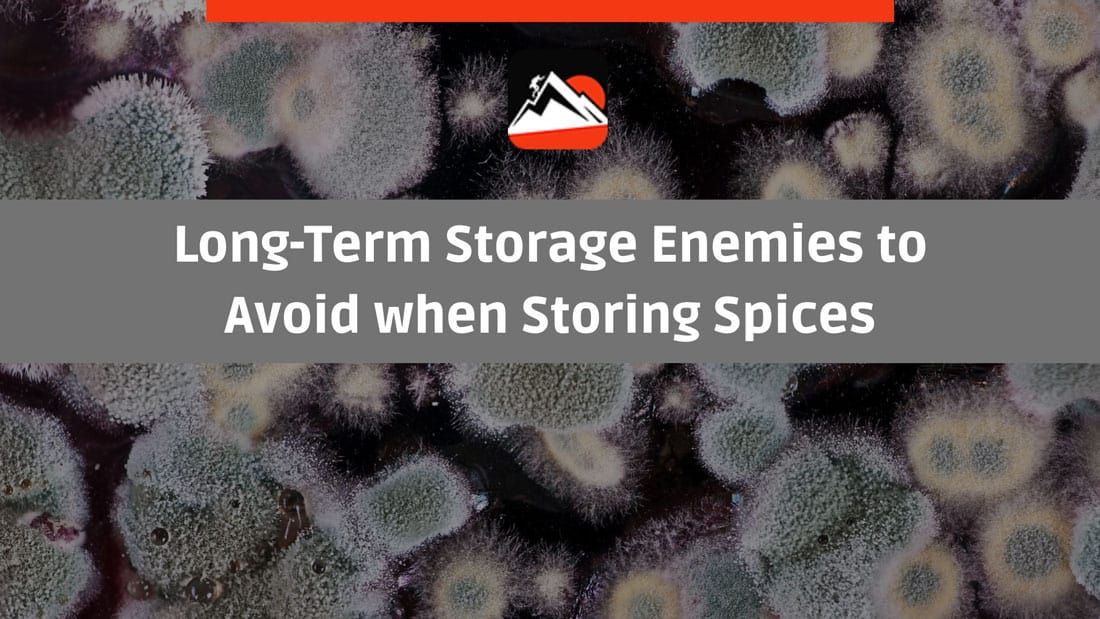
mold growing in flat surface

Contents
When most people think about preparedness, they think about stockpiling non-perishable food items and water. However, there is one other item that is often overlooked: spices. While they may not seem like an essential item, having a supply of spices on hand can make all the difference in a long-term emergency situation.
Most people don’t think too much about their spices. They might buy them in bulk when they’re on sale or replenish their supply when they run out, but other than that, they’re not given much thought. However, there are some good reasons to take a more proactive approach to spice storage.
When it comes to emergency preparedness, food is always top of mind. But what about the spices that can make those emergency meals more palatable?
Storing spices long-term is a good idea that is often overlooked. However, with a little planning, you can make sure your spices are fresh and ready to use when you need them most.
How Long do Spices Last?
When it comes to spices, how long they last really depends on the type of spice.
- Whole spices, like cloves and nutmeg, can last for two to three years.
- Leafy herbs, like basil and oregano, have a shorter shelf life and will only last for six to eight months.
- Ground spices, like cinnamon and turmeric, have an even shorter shelf life of one to two years.
We also recommend reading our article about storing baking soda for emergencies.
Which is better for Long-Term Storage?
When it comes to spice storage, there are two schools of thought: whole spice vs. ground spice. Both have their proponents, but which is the better option for long-term storage?
To answer this question, we must first understand how spices lose their flavor. Flavors come from essential oils, and these oils begin to evaporate as soon as the spice is ground. As a result, ground spices will always be more potent in the short term, but they will also lose their flavor more quickly over time. In contrast, whole spices take longer to release their flavors, but they will retain their potency for a more extended period.
So, if you’re looking to keep your spices fresh for as long as possible, whole spices are the way to go. However, they can be more difficult to use, and you may need to invest in a good grinder. On the other hand, if convenience is a priority, then ground spices are the way to go. Just be sure to buy them in smaller quantities so that you can use them up before they lose their flavor.
Long-Term Storage Enemies to Avoid when Storing Spices
Long-term spice storage has four main enemies: light, heat, moisture, and air.
- Light will cause colors to fade and flavors to degrade.
- Heat speeds up the evaporation of essential oils, resulting in loss of flavor.
- Moisture can cause spices to clump and foster the growth of mold and bacteria.
- And finally, air causes oxidation, which can make spices taste stale.
Check out the proper way to store tea long term with our guide.
Best Spices to Store for Emergency Survival
When it comes to emergency survival, it’s essential to make sure you have the right supplies on hand. This includes having a good stock of non-perishable food items and a variety of spices to help make your meals more enjoyable.
But with so many options out there, it can be tough to know which spices to store. So here are a few tips to help you choose the best spices for emergency survival:
- First, take inventory of the spices you regularly use in your cooking. This will help you narrow down the list of must-have spices.
- Then, consider the types of food you typically eat in an emergency situation. For example, if you’re mostly eating canned goods and dried foods, you’ll want to focus on spices that can add flavor without requiring cooked or fresh ingredients.
- Finally, choose the spices you enjoy the most. There’s no point in stockpiling spices you don’t actually like using.
By following these guidelines, you can ensure that you have the best possible selection of spices for emergency survival.
Which is Better to Store: Spice Mixes vs. Single Spices
When it comes to spices, there are two schools of thought: pre-mixed spice blends or single spices that you can mix yourself. But, of course, there are pros and cons to both approaches.
On the one hand, pre-mixed spice blends can be convenient - you don’t need to measure out several different spices, and they can often be more flavorful than a blend you make yourself. On the other hand, however, some pre-mixed spice blends contain unhealthy ingredients like MSG, which can be more expensive than buying single spices.
If you choose to buy single spices, you can make your own spice mixes beforehand and store them in airtight containers. This way, you know exactly what’s in your mix, and you can tailor it to your own taste buds. Plus, buying single spices is usually cheaper than buying pre-mixed blends.
So, at the end of the day, it’s up to you which approach you want to take.
Learn how to store oats long term by clicking here.
Why You Should Consider Storing Spices Long-Term
At some point, we’ve all been there. For example, you’re in the middle of cooking a dish and realize you’re out of one of the key ingredients. Or, you go to use a spice that you thought would last forever, only to find it’s gone bad.
While these situations can be frustrating, they’re also entirely avoidable with a little bit of planning. If you often cook with spices, consider investing in a long-term storage solution.
Here are a few reasons why it’s worth taking the time to do so:
- First, storing spices long-term can help reduce food fatigue. You’ll be more likely to experiment with new recipes and flavor combinations when you have a pantry full of fresh spices. This can be a great way to add some variety to your diet and prevent mealtime from becoming boring.
- Second, using fresh spices can also boost your morale when cooking. When you know you have high-quality ingredients on hand, it’s easier to get excited about making dinner. This is especially true if you love trying new recipes and experimenting in the kitchen.
- Finally, long-term storage of spices can also help you make the most of your ingredients. For example, if you have a lot of rice and beans in your pantry, you can use different spices to make them taste different each time you cook them. This can help prevent mealtime from becoming monotonous, even if you’re eating the same things over and over again.
Long-term storage is definitely worth considering if you frequently use spices in your cooking. By taking the time to invest in a good storage solution, you’ll be able to enjoy fresh, flavorful spices for years to come.
Spices Long-Term Storage Options

Herbs and spices are a great way to add flavor to your cooking, but they can be tricky to store. If you’re not careful, they can quickly lose their potency. Here are a few tips for storing your spices so that they stay fresh for as long as possible.
Canning Jars
Canning jars are a great option because they are airtight and will protect your spices from moisture and light. The key is to ensure the jars are clean and dry before packing them.
You also want to make sure the spices are fresh - meaning they haven’t been sitting in your cupboard for years. When it comes to packing the jars, you don’t want to pack them too tightly. Leave a little room so the air can circulate and prevent the spices from clumping together.
And finally, make sure you label the jars so you know what’s inside. Nothing is worse than reaching for the cinnamon only to grab a handful of cumin!
By following these simple tips, you can ensure your spices will stay fresh and flavorful for years to come.
Mylar Bags with Oxygen Absorbers
Mylar bags are a great alternative. They’re airtight and lightproof, which means your spices will stay fresh for longer. Plus, you can use oxygen absorbers to remove any remaining oxygen from the bag.
Oxygen absorbers are small packets that remove oxygen from the air, creating an inhospitable environment for bacteria and mold. By removing the oxygen, oxygen absorbers help prolong the shelf life of spices - and since they’re sealed in Mylar bags, your spices will also be protected from moisture.
To use this storage method, simply place your spices in Mylar bags and add an oxygen absorber packet. Then seal the bag tightly and store it in a cool, dark place. When you’re ready to use your spices, simply open the bag and remove the amount you need - no need to worry about the rest going bad before you have a chance to use it.
With this simple storage solution, you can buy your spices in bulk and be confident that they’ll stay fresh until you’re ready to use them.
Check out the right way to store powdered milk for survival here.
Vacuum Sealed Bags
Vacuum-sealing is one of the best ways to keep herbs and spices fresh for the long term. Vacuum-sealed bags prevent oxygen and moisture from damaging the delicate flavor molecules of your spices. Not only does this reduce waste, but it also means you’ll always have fresh spices on hand when you need them.
If you’re serious about your spices, invest in a good vacuum sealer and keep your collection well-stocked. Your taste buds will thank you!
Tips to Make Sure Your Spices Last Longer
As any cook knows, spices are essential for adding flavor to food. However, they can also be expensive, and it can be frustrating to waste money on spices that go bad before you have a chance to use them. So here are a few tips to help you get the most out of your spices:
- Label your spices with the date you bought them. This will help you track how long they’ve been in your pantry and ensure you use them before they go bad.
- Use FIFO to manage your spices. First In, First Out is a system where you use the oldest spices first and save the newer ones for later. This way, nothing gets lost in the back of your pantry, and everything gets used before it expires.
- Invest in a good spice grinder. A quality grinder will help you get the most flavor out of your spices by grinding them fresh when you need them.
With these simple tips, you can make sure your spices last longer and always have fresh, flavorful spices on hand.
Conclusion
As you can see, storing spices long-term is a great idea. Being prepared in the event of an emergency is always a good idea, and having a stockpile of spices on hand can help you be self-sufficient in a pinch.
Plus, it’s just smart to have a few extra spices around for cooking emergencies - we’ve all had that moment where we realize we’re out of something essential right in the middle of making dinner.
So go ahead and stock up on your favorite spices - you’ll be glad you did!



